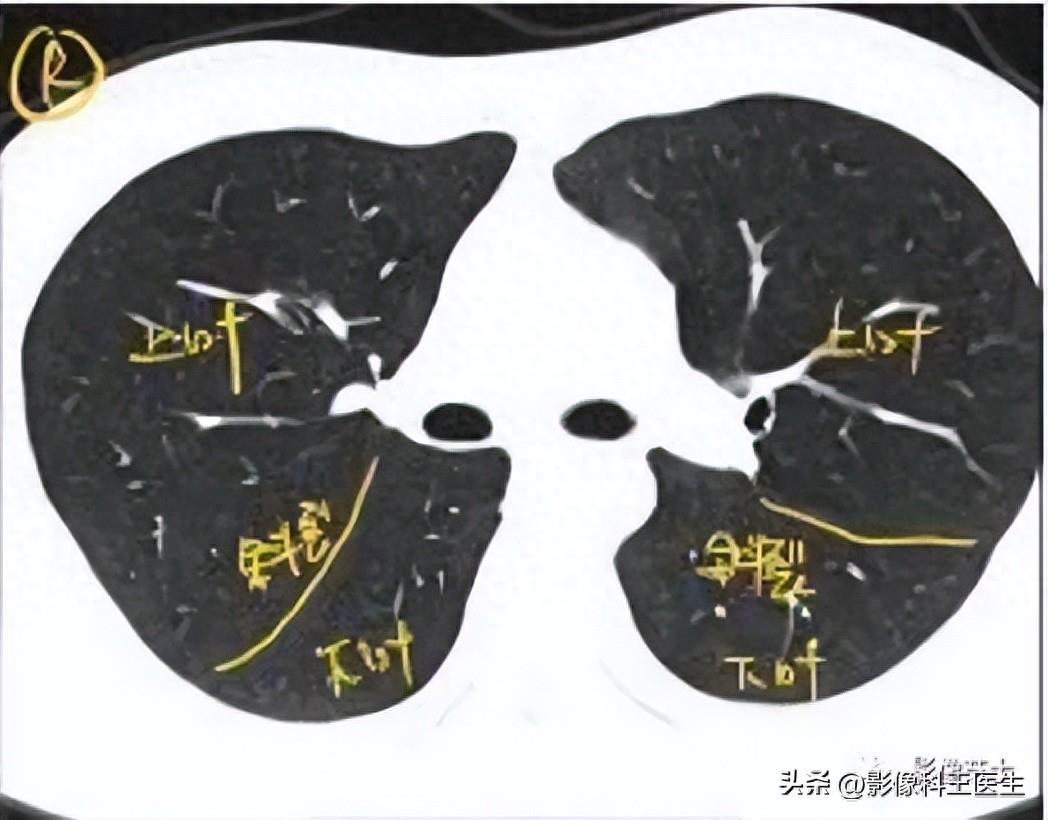
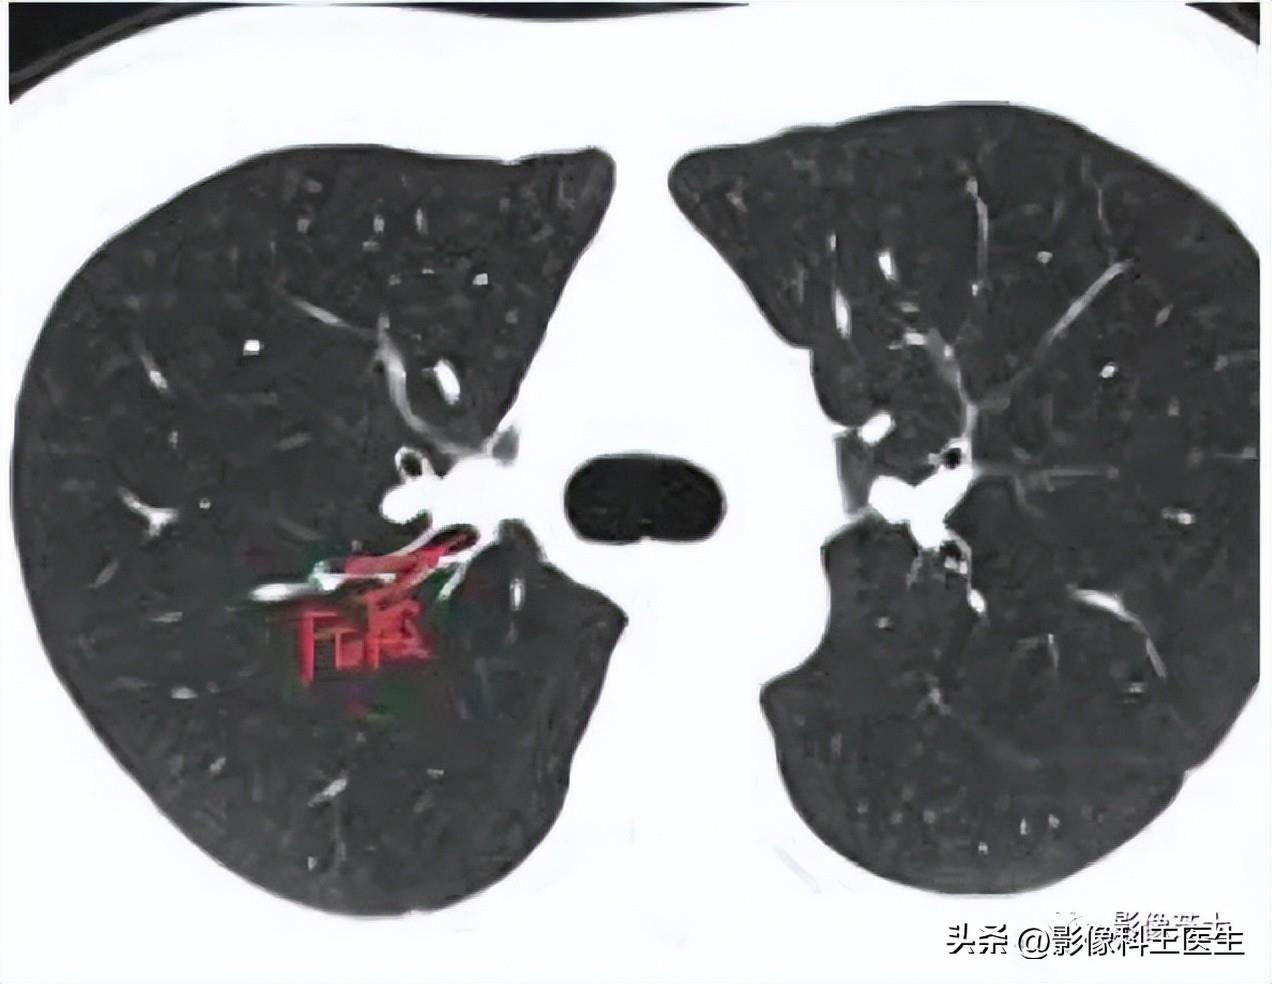

山西排名前十的职业技术学校
2025-10-13 01:11:42
肺段、支气管分段CT解剖(详细标注)
肺部解剖分叶分段CT
“
01
分叶
先切到斜裂,后水平裂

左二右三
“
02
支气管分段
一,左肺

又长又细,走行缓和
左上叶




舌段支气管



上舌段支气管 下舌段支气管
舌段就是对应右肺的中叶:当右肺的中叶出现的时候,左肺的舌段就应该出现了,且上舌段位置较下舌段靠上,先出现,两者距离近。
下叶支气管





左下叶一开始出现的背段支气管

基底段支气管
二、右肺

又短又粗,走行陡峭
上叶支气管

尖段支气管 前段支气管 后段支气管

中间支气管
中叶支气管


下叶支气管




肺的分段















2025-10-13 01:11:42
2025-10-13 01:09:26
2025-10-13 01:07:10
2025-10-13 01:04:54
2025-10-13 01:02:38
2025-10-13 01:00:23
2025-10-13 00:58:06
2025-10-11 11:04:11
2025-10-11 11:33:50
2025-10-11 10:59:40
2025-10-11 10:57:24
2025-10-11 10:55:09
2025-10-11 10:52:53
2025-10-11 10:50:38
2025-10-11 10:48:22
2025-10-11 10:46:07
2025-10-11 10:43:51
2025-10-11 00:21:07
2025-10-11 00:18:51
2025-10-11 00:16:35